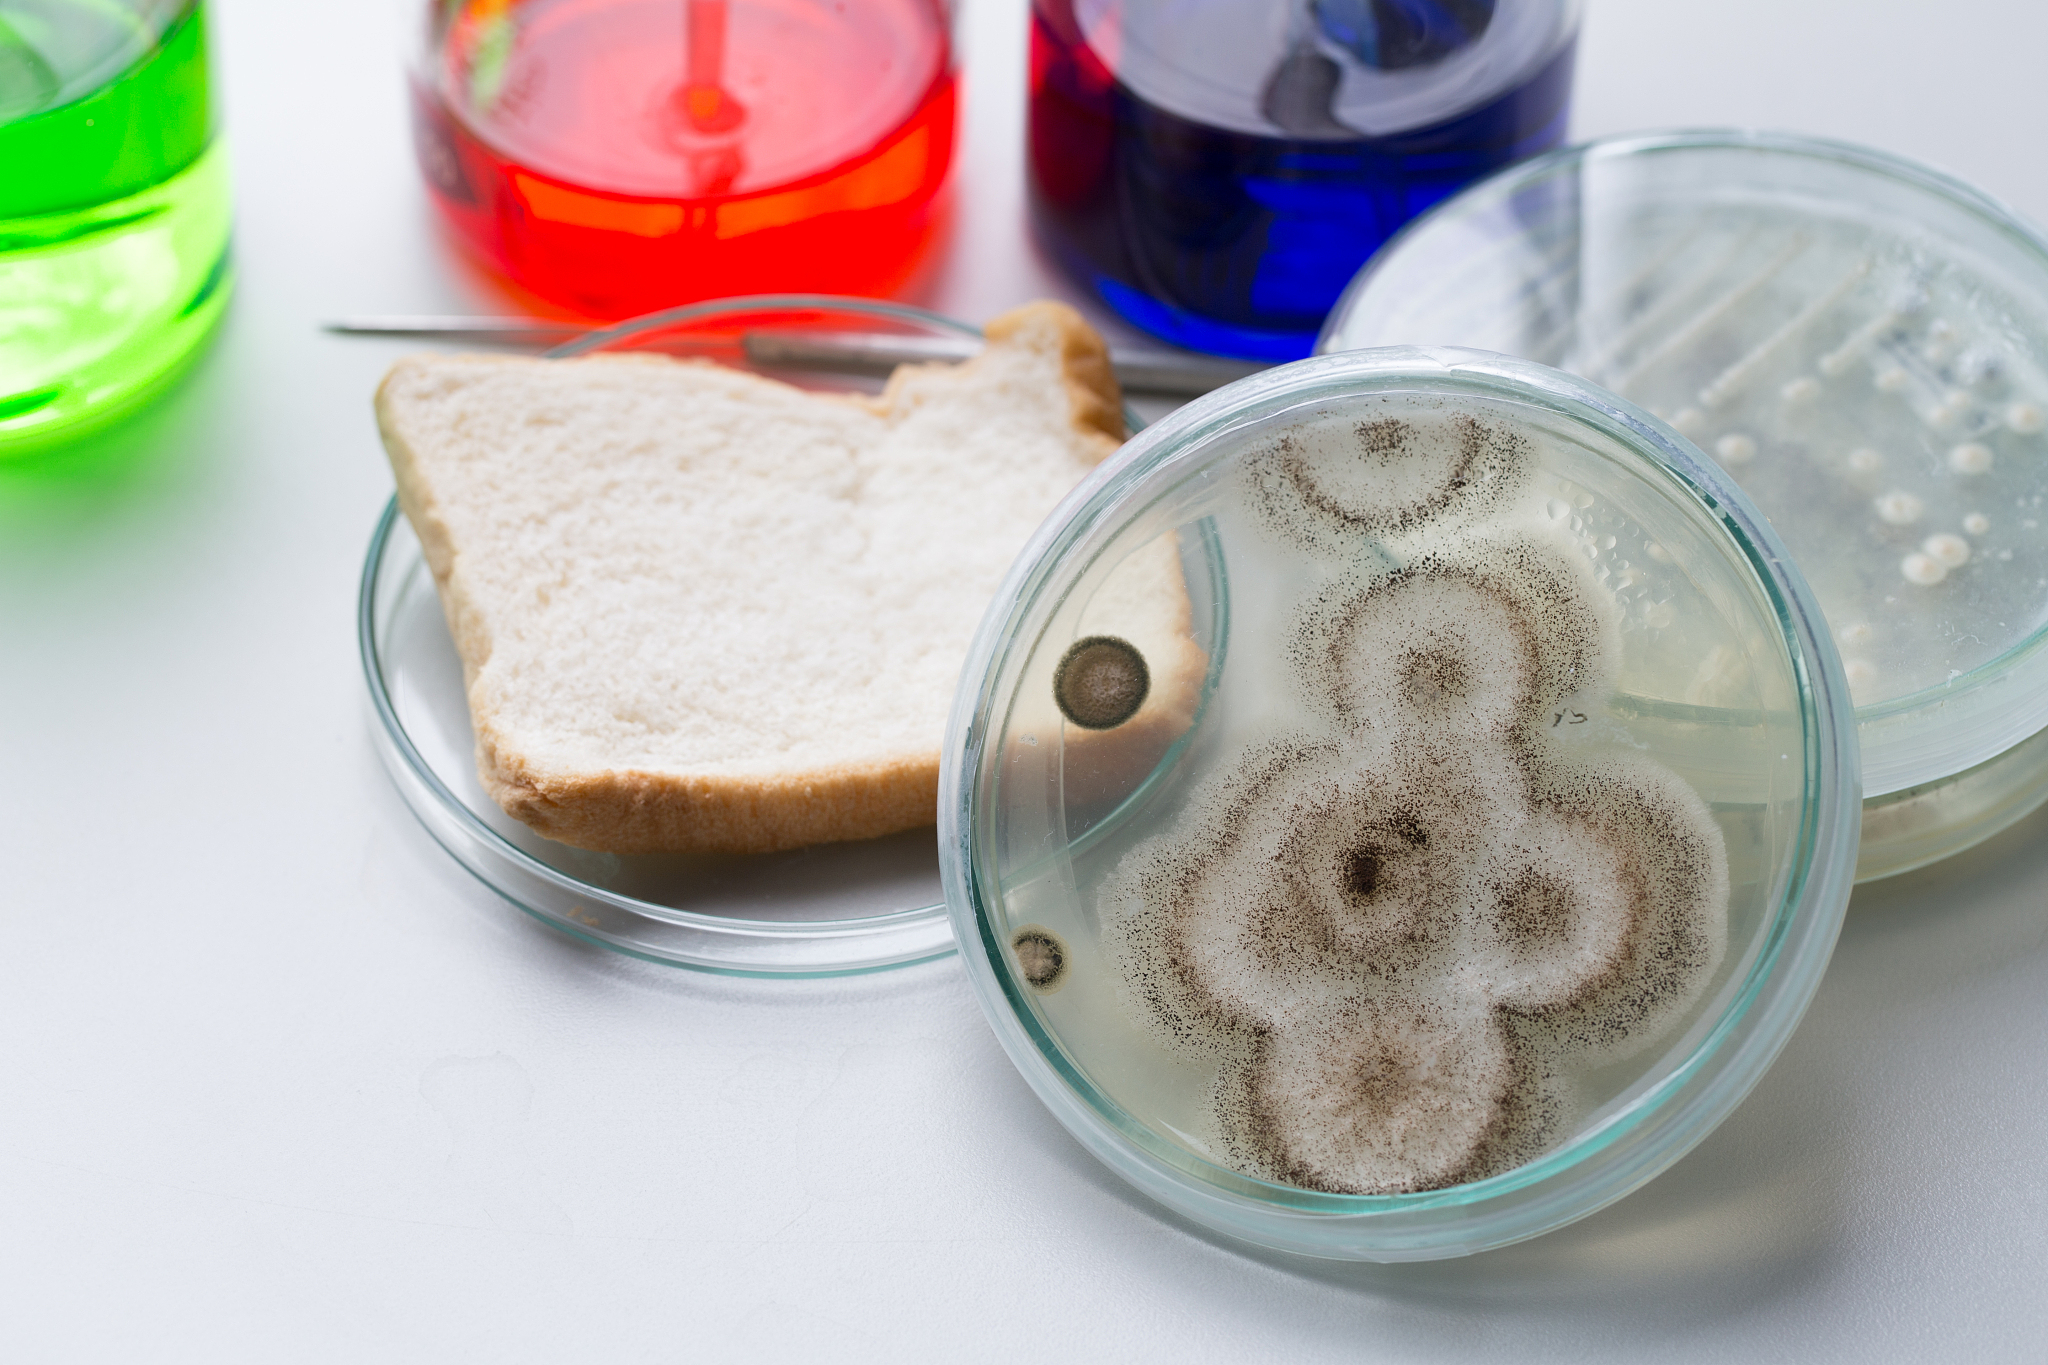
蛋糕盒上的霉菌会扩散吗？- 解密霉菌传播途径

蛋糕盒上的霉菌会扩散吗?- 解密霉菌传播途径
蛋糕盒上的霉菌会扩散吗?
你是否遇到过这样的情况:打开蛋糕盒,发现里面长了霉菌,而盒子外部看起来却很干净。这是否意味着霉菌只会在蛋糕内部生长,不会扩散到盒子外面呢?
答案是不一定。
根据生物学原理,霉菌是一种单细胞或多细胞的真菌,需要适宜的温度、湿度和养分才能生长繁殖,并倾向于在阴暗环境中生长。
因此,如果蛋糕盒子的环境也符合霉菌的生长条件,比如潮湿、温暖、避光,那么霉菌很有可能从蛋糕中生长出来,蔓延至盒子外。反之,如果盒子干燥、低温,霉菌就难以存活和扩散。
此外,即使盒子外部没有明显霉斑,也并不代表完全安全。因为蛋糕上的霉菌可能已经释放出孢子,这些孢子可以在空气中漂浮,一旦落在适宜的环境中,就可能萌发并生长,导致新的霉菌污染。
为了避免霉菌扩散,建议:
- 将蛋糕存放在干燥、阴凉、通风处。
- 及时清理蛋糕盒子,避免残留物滋生霉菌。
- 发现蛋糕发霉,应立即丢弃,不要食用。
通过了解霉菌的生长习性和传播途径,并采取正确的预防措施,才能有效保障食品安全,守护家人健康。
原文地址: http://www.cveoy.top/t/topic/jvDF 著作权归作者所有。请勿转载和采集!